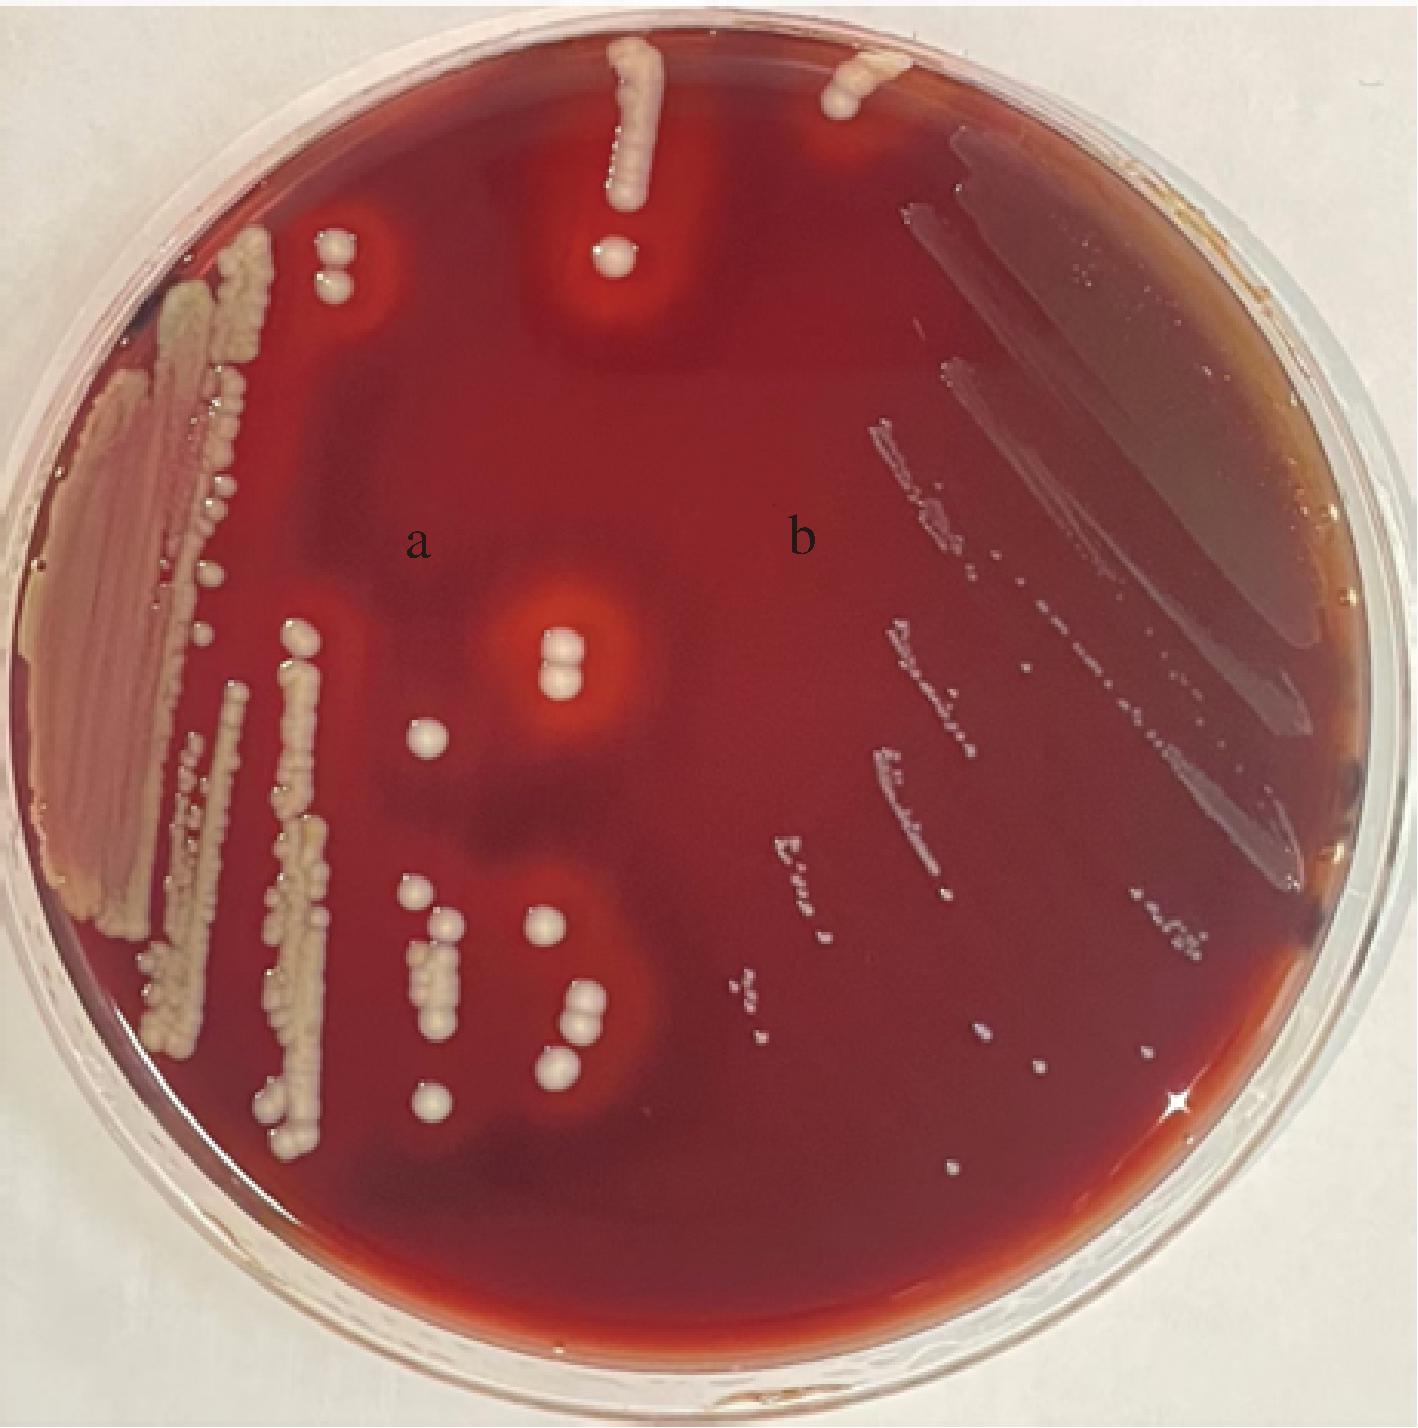
width=259,height=261,dpi=110

乳酸菌是利用可发酵的碳水化合物产生大量乳酸的细菌的总称[1]。作为一种重要的食品微生物,广泛应用于食品发酵行业,比如乳制品、肉制品、泡菜等。具有耐盐特性的乳酸菌作为一种新型微生物资源,对发酵产品口感、品质的提高及生产工艺的改善具有非常重要的作用[2]。因此,分离筛选具有优良耐盐特性的乳酸菌菌株对于乳酸菌科学研究和产品开发具有重要理论意义和应用价值。目前对于耐盐乳酸菌的筛选工作仍以高盐环境为主。刘廷菊[3]从贵州锦屏腌鱼中分离出的6株乳酸菌中筛选出2株植物乳植杆菌(Lactiplantibacillus plantarum),可耐受质量分数为12%的NaCl。曲玲童[4]从锦州腌渍小黄瓜中分离鉴定的20株乳酸菌中筛选出1株L.plantarum,具有良好的发酵性能并且能在NaCl质量分数为7%的培养基中正常生长。但也有研究表明,有些耐盐乳酸菌能从乳制品中获得,例如万金敏等[5]从西藏牦牛奶渣中分离筛选出4株乳酸菌在NaCl质量分数为9%时表现出良好的耐盐特性。文华英等[6]从西藏传统发酵乳中利用低温筛选出的2株副干酪乳酪杆菌(Lacticaseibacillus paracasei)在NaCl质量分数为8%时表现出良好的耐盐能力。HASSAN等[7]从传统巴基斯坦酸奶中分离出的瑞士乳杆菌(Lactobacillus helveticus)和L.plantarum有较好的耐盐特性,其中的L.helveticus LBh5能够耐受7%的NaCl质量分数。
牦牛乳制品产地一般位于高寒地区,其中的乳酸菌资源非常丰富。云南省香格里拉市位于云南西北部,滇川藏三省区的交界处,地处迪庆香格里拉腹心地带,是云南最大的天然牧场。当地牧民饮用牦牛乳补充营养、抵御寒冷[8]。独特的地理位置、气候特征和饮食习惯孕育了宝贵的乳酸菌资源。不同地区牦牛乳中优势乳酸菌存在差异,且与不同地理位置、气候条件及不同发酵方式相关。例如,青海地区牦牛乳中的优势菌为德氏乳杆菌保加利亚亚种(Lactobacillus delbrueckii subsp.bulgaricus)、干酪乳酪杆菌(Lacticaseibacillus casei)[9];川西高原牦牛乳中的优势菌为L.casei和鼠李糖乳酪杆菌(Lacticaseibacillus rhamnosus)[10];西藏地区牦牛乳中的优势菌为L.plantarum、乳酸片球菌(Pediococcus acidilactici)[11]。而云南香格里拉地区牦牛乳中乳酸菌的研究匮乏,对于优良耐受性菌株筛选的报道较少。
因此,本研究采用传统纯培养方法结合16S rRNA测序技术对云南香格里拉地区5份鲜牦牛奶和5份传统发酵牦牛奶中的乳酸菌种进行分离纯化及鉴定,并对分离株进行耐盐的初步筛选,对筛选菌株进行益生特性试验和安全性评价。以期为耐盐乳酸菌发酵剂的开发提供种质资源,为高盐发酵产品的开发提供基础数据和理论支撑。
1 材料与方法
1.1 实验材料
1.1.1 样品及其来源
本研究对采集自云南香格里拉地区的10份牦牛奶样品进行分离鉴定,样品包括5份鲜牦牛奶和5份酸牦牛奶,采样地环境条件极端,海拔高度均在3 000 m 以上。样品采集时,用无菌吸管吸取2~5 mL 鲜牦牛奶和酸牦牛奶于加有0.5 g保护剂[m(淀粉)∶m(CaCO3)=50∶1]的无菌采样管中。收集后,低温运送至实验室,进行乳酸菌的分离。
1.1.2 材料与试剂
MRS培养基、强化梭菌培养基(reinforced medium for Clostridia, RCM)、营养肉汤培养基(nutrient agar, NA)、脱纤维无菌绵羊血,青岛海博生物技术有限公司;琼脂、胰蛋白酶、胃蛋白酶,北京康倍斯科技有限公司;NaCl试剂,福晨天津化学试剂有限公司;细菌基因组DNA提取试剂盒,天根生化科技有限公司;牛胆盐,德国Merck KGaA公司;抗菌药物药敏纸片,杭州微生物试剂有限公司。
1.2 仪器与设备
SX-500型全自动高压灭菌锅,日本Tomy Digital Biology公司;ZHJH-C1214C超净工作台,上海智城仪器制造厂;AR2202CN电子天平,奥豪斯仪器上海有限公司;CX33显微镜,日本OLYMPUS公司;5810R台式高速离心机、KDC-1044立式低速离心机,德国Eppendorf公司;PTC-200型PCR仪,美国Life Technologies公司。
1.3 实验方法
1.3.1 牦牛源乳酸菌的分离鉴定
1.3.1.1 乳酸菌的分离纯化及保藏
采用10倍梯度稀释法对样品进行梯度稀释[12]。选取合适的稀释梯度移取200 μL涂布于MRS和RCM固体培养基上。在厌氧条件下37 ℃恒温培养48 h后,挑取形态特征不同的单个菌落于相应的固体培养基上进行划线纯化。选取革兰氏染色阳性、过氧化氢酶阴性且形态均一的球菌和杆菌保存于脱脂乳冻菌保护剂(脱脂乳:8 g,蒸馏水:72 mL;酵母粉:2 g,蒸馏水:18 mL)中,液氮急冷后保存于-80 ℃。
1.3.1.2 乳酸菌分子生物学鉴定
使用细菌基因组DNA提取试剂盒提取菌株的DNA,用PCR扩增仪进行16S rRNA基因扩增,PCR扩增体系及条件参考YU等[13]方法进行。扩增产物送至上海美吉生物医药科技有限公司进行测序。将测序得到的DNA序列在NCBI(https://www.ncbi.nlm.nih.gov/)中进行BLAST同源性比对,初步确定菌株的分类学地位。并在LPSN数据库下载对应菌种模式株的16S rRNA基因序列,使用MEGA 7.0软件构建系统发育树[14],进一步准确确定菌株的分类学地位。
1.3.2 乳酸菌的初步筛选
将170株分离株活化后连续培养至第3代,按照4%(体积分数)的接种量接种于NaCl质量分数为4%的MRS液体培养基中,37 ℃厌氧培养24 h。分别测定0 h和24 h的OD600nm值,并计算2个时间点OD600nm差值(ΔOD600nm)。本实验以干酪乳酪杆菌Zhang(L.casei Zhang)为对照组[15],通过比较各菌株与L.casei Zhang的生长量差值,初步筛选出25株ΔOD600nm大于L.casei Zhang的菌株。继续按照上述方法对25株乳酸菌进行8%NaCl质量分数的复筛。每组实验3个平行,取平均值。
1.3.3 菌株对盐的耐受性试验
将初步筛选出的菌株培养至第3代,按照4%(体积分数)的接种量分别接种于NaCl质量分数为0%、2%、4%、6%、8%、10%、12%、14%、16%、18%的MRS液体培养基中[16]。厌氧条件下37 ℃培养24 h,进行乳酸菌的活菌计数。
1.3.4 菌株对人工胃肠液耐受性试验
人工胃液(pH 2.5,3.0 g/L胃蛋白酶)与肠液(pH 8.0,1.0 g/L胰蛋白酶,18 g/L胆盐)的配制及耐受性试验参照LIU等[17]所用的方法进行。将筛选菌株培养至第2代,对其进行扩大培养。37 ℃厌氧培养24 h,对3代菌株进行离心(4 200 r/min,5 min),弃去上清液,收集菌体细胞,加入5 mL PBS振荡混匀得到菌悬液。用平板计数法对菌悬液进行活菌计数,即为0 h的活菌数。取1 mL菌悬液于9 mL人工胃液中,37 ℃水浴3 h后测定活菌数,即为胃液3 h的活菌数,同时取1 mL胃液转接入9 mL 人工肠液中,37 ℃水浴分别测定菌株在肠液中水浴4 h与8 h后(7 h和11 h)的活菌数。记录0、3、7、11 h的活菌数,随后计算菌株存活率,如公式(1)所示:
存活率![]()
(1)
式中:N0为0 h的活菌数,CFU/mL;N1为3、7、11 h的活菌数,CFU/mL。
1.3.5 抑菌试验
将培养至3代的待测菌离心(4 200 r/min,5 min),弃掉菌体,保留上清液制备成菌悬液,然后调节指示菌浓度为106 CFU/mL。使用牛津杯扩散法[18],按1%接种量将指示菌接种到NA培养基中混匀后,倾注平板,静置5 min后将牛津杯放置平板中。待其完全凝固后,每个牛津杯中加入150~200 μL的上清液,于4 ℃条件下使上清液扩散10 h后37 ℃培养18 h,测量抑菌圈的直径。每个致病菌进行3次重复实验。
指示菌为大肠埃希氏菌CICC 23657T、肠沙门氏菌肠亚种肠炎血清型CICC 10982T、金黄色葡萄球菌ATCC 12600T。菌株均购买于中国工业微生物菌种保藏管理中心(China Center of Industrial Culture Collection, CICC)。
1.3.6 菌株L. paracasei IMAU13337安全性评价
1.3.6.1 抗生素敏感性试验
参考周闯等[19],运用纸片扩散法(K-B法)测定菌株对20种抗菌药物的敏感性。取100 μL的IMAU13337菌悬液均匀涂布于MRS固体培养基上,再将药敏片贴在培养基表面。37 ℃厌氧培养24 h。依据药敏片周围抑菌圈大小来判断菌株的药物敏感性。
1.3.6.2 溶血性试验
将培养至3代的IMAU13337划线于体积分数为5%的脱纤维绵羊血固体平板上,于37 ℃下倒置培养24~48 h。以金黄色葡萄球菌作为阳性对照,进行菌落周围溶血圈的观察及记录[20]。菌落周围有透明的溶血环为β-溶血;菌落周围有草绿色环为α-溶血;菌落周围没有明显溶血变化为γ-溶血,即无溶血性。
1.4 数据处理
所有实验设置3次平行,实验数据用“平均值±标准差”表示。利用SPSS R26.0对数据进行统计分析,采用单因素方差分析(ANOVA)检验,P<0.05认为差异有统计学意义。采用Origin 2018软件进行绘图。
2 结果与分析
2.1 乳酸菌的分离鉴定结果
10份牦牛乳样品中共分离出170株乳酸菌(表1)。经16S rRNA序列鉴定,隶属于7个属、9个种(图1)。7个属分别为乳杆菌属(Lactobacillus)、迟缓乳杆菌属(Lentilactobacillus)、乳酪杆菌属(Lacticaseibacillus)、乳植杆菌属(Lactiplantibacillus)、短促生乳杆菌属(Levilactobacillus)、粘液乳杆菌属(Limosilactobacillus)和链球菌属(Streptococcus)。优势菌种为L.helveticus,共80株,占总分离株的47.1%。其次为食二酸迟缓乳杆菌(Lentilactobacillus diolivorans)和L.paracasei,分别为40株和21株,各占总分离株的23.5%和12.4%。

图1 部分乳酸菌分离株16S rRNA基因序列系统发育树
Fig.1 Phylogenetic tree of 16S rRNA gene sequence of partial lactic acid bacteria isolated strains
表1 牦牛乳样品分离株的分离鉴定汇总结果 单位:株
Table 1 Summary results of isolation and identification of yak milk samples isolates

菌株名称不同培养基中分离的菌株数量RCMMRS总计L.helveticus512980L. paracasei12921L.diolivorans142640开菲尔慢生乳杆菌(Lentilactobacillus kefiri)3710发酵粘液乳杆菌(Limosilactobacillus fermentum)101口腔链球菌(Streptococcus oralis)202L.plantarum112德氏乳杆菌(Lactobacillus delbrueckii)01313短发酵剂乳杆菌(Levilactobacillus brevis)011总计8486170
分析2种分离源的菌群组成发现(图2),其中优势菌属均为Lactobacillus和Lentilactobacillus。鲜牦牛奶中的Lactobacillus和Lentilactobacillus分别占菌属总数的56.96%和17.72%。而酸牦牛奶中的Lactobacillus和Lentilactobacillus分别占菌属总数的52.74%和39.56%。从鲜牦牛奶和酸牦牛奶中均分离得到7种乳酸菌,优势菌种均为L.helveticus,并且乳杆菌是牦牛乳样品中的优势菌群。LIU等[21]通过纯培养方法和16S rRNA测序分析发现从云南地区酸乳清样品中分离出的优势菌种是L.helveticus。杨子燕等[22]从云南迪庆传统发酵乳制品中分离出的优势菌群是乳杆菌。均与本研究的结果一致。

a-乳酸菌属的数量;b-乳酸菌种的数量
图2 不同分离源中乳酸菌的种类与数量
Fig.2 The types and quantities of lactic acid bacteria in different sources
2.2 乳酸菌的初步筛选结果
先将170株乳酸菌在4% NaCl质量分数的MRS中进行初筛。以对照菌株L.casei Zhang为筛选标准,通过比较170株乳酸菌与L.casei Zhang的生长量差值,初步筛选出25株生长量超出L.casei Zhang的菌株。再将25株乳酸菌在8%NaCl质量分数的MRS中进行复筛。最终筛选出3株L.paracasei,其在8%的NaCl质量分数下的生长量同样超出对照菌株L.casei Zhang。其中IMAU13337的ΔOD600nm值最高,达到0.183,其次是IMAU13368和IMAU13429,ΔOD600nm值分别为0.169和0.136,具体的筛选结果如图3所示。

a-乳酸菌在4%NaCl质量分数下的ΔOD600nm值; b-乳酸菌在8%NaCl质量分数下的ΔOD600nm值
图3 菌株的初筛结果
Fig.3 The primary screening results of strains
2.3 菌株对盐的耐受能力试验
将筛选得到的3株L.paracasei以初始浓度为107 CFU/mL分别接种于不同NaCl质量分数的培养基中[23],培养24 h后进行活菌计数。结果如图4所示,当NaCl质量分数低于4%时,活菌数变化不大,说明该浓度对菌株生长影响不大;当NaCl质量分数高于4%时,活菌数呈下降趋势。并且NaCl质量分数越高,活菌数下降越明显。菌株IMAU13429在10%的NaCl质量分数下曲线开始趋于平稳;IMAU13368在12%的NaCl质量分数下曲线开始趋于平稳;而IMAU13337在16%的NaCl质量分数下曲线开始趋于平稳。虽然3株菌均受到不同程度的抑制,但是在18%的NaCl质量分数下,活菌数保持在107 CFU/mL以上,说明菌株在此浓度下仍有活性。

图4 菌株IMAU13368、IMAU13337和IMAU13429对NaCl的耐受性
Fig.4 The tolerance of IMAU13368, IMAU13337, and IMAU13429 to NaCl
高盐浓度是乳酸菌在发酵中会遇到的一个主要环境应力。盐浓度过高会对乳酸菌的结构和生理上造成不同程度的影响[24],例如会导致细胞内水分外流、细胞胞质分离、细胞停止生长甚至死亡。因此乳酸菌能够在高盐环境中存活和生长对于发酵食品至关重要。有文献报道[25],有些乳酸菌可以耐受6%~18%的NaCl质量分数,其中乳酸菌的不同生境是其耐盐差异的主要原因[26]。例如南晓芳[27]从豆歧和腐乳中分离出31株乳酸菌,经过不同NaCl质量分数的筛选,最终筛选出5株可以在12%NaCl质量分数下生长的菌株。李梓铭[28]从盐渍辣椒分离出的菌株中最终筛选出1株L.plantarum Ly-4和1株肠球菌(Enterococcus)Ly-2能够在18%NaCl质量分数的培养基中正常生长。目前对于牦牛乳中乳酸菌的耐盐能力研究较少,本研究筛选出的菌株IMAU13368、IMAU13337、IMAU13429具有较好的耐盐特性,可以作为潜在的耐盐菌株用于进一步的益生特性研究。
2.4 菌株对人工胃肠液的耐受能力试验
评价益生菌的重要前提是其能否在肠道中定植生长并发挥益生功能[29]。因此对3株潜在耐盐菌株的人工胃肠液耐受性进行了评价。L.casei Zhang已被证实具有较强的胃肠液耐受能力[30],因此以L.casei Zhang作为对照菌株,结果如表2所示。菌株IMAU13368的人工胃肠液耐受性较差,胃液3 h的存活率为43.27%,肠液4 h与8 h的存活率分别为26.05%与23.61%。菌株IMAU13429的人工胃肠液耐受性较好,胃液3 h的存活率为57.24%,肠液4 h与8 h的存活率分别为51.84%与48.77%。菌株IMAU13337的人工胃肠液耐受能力最强,模拟胃液消化3 h的存活率为72.43%;模拟肠液消化4 h的存活率为62.50%,接近对照菌株;模拟肠液消化8 h 的存活率为57.79%,仅次于对照菌株L.casei Zhang。并且显著高于IMAU13368和IMAU13429(P<0.05)。
表2 副干酪乳酪杆菌对人工胃肠液的耐受能力测定结果
Table 2 The tolerance of Lacticaseibacillus paracasei to simulated gastric and intestine juice

注:同一行不同小写字母表示显著差异(P<0.05)(下同)。
菌株名称人工胃液(pH 2.5)人工肠液(pH 8)活菌数(×109 CFU/mL)存活率/%活菌数(×109 CFU/mL)存活率/%0 h3 h3 h/0 h7 h11 h7 h/0 h11 h/0 hZhang11.6±0.159.80±0.2584.48a7.51±0.297.27±0.2364.74a62.67aIMAU1333713.6±0.209.85±0.4772.43b8.50±0.247.86±0.3062.50a57.79bIMAU1342916.3±0.099.33±0.4457.24c8.45±0.277.95±0.4051.84b48.77cIMAU1336811.9±0.175.15±0.4343.27d3.10±0.282.81±0.1226.05c23.61d
2.5 菌株的抑菌能力
抑菌能力是益生菌筛选的主要指标之一。具有抗菌活性的乳酸菌可以预防胃肠道的感染、也可以作为食品的天然防腐剂[31]。所以对IMAU13337、IMAU133368、IMAU13429进行3种常见致病菌(金黄色葡萄球菌ATCC 12600T、大肠杆菌CICC 23657T、肠沙门氏菌肠亚种肠炎血清型CICC 10982T)的抑菌能力评价。结果如表3所示。3株L.paracasei对3种致病菌均有不同程度的抑制作用。IMAU13337、IMAU13368、IMAU13429对金黄色葡萄球菌ATCC 12600T的抑菌能力最强,直径分别为(20.14±0.44)、(18.34±0.50)、(16.65±0.24) mm。综合评价发现,IMAU13337的抑菌能力显著高于IMAU13429和IMAU13368(P<0.05)。因此,选择IMAU13337进行安全性评价。
表3 IMAU13337、IMAU13368和IMAU13429的抑菌直径 单位:mm
Table 3 The bacteriostatic diameter of IMAU13337, IMAU13368, and IMAU13429

指示菌株IMAU13337IMAU13429IMAU13368金黄色葡萄球菌ATCC 12600T20.14±0.44a18.34±0.50b16.65±0.24c大肠杆菌 CICC 23657T14.58±0.32a13.92±0.34b13.36±0.15c肠沙门氏菌肠亚种肠炎血清型CICC 10982T15.47±0.85a11.37±0.23c12.60±0.45b
2.6 菌株的安全性评价
2.6.1 抗生素敏感性试验
随着乳酸菌应用的扩大,人们越来越关注菌株的安全性,因为抗生素耐药基因具有转移的风险,影响人体的健康和安全。目前,体外实验仍然是评估安全性的主要方法,包括抗生素耐药性和溶血性的评估[32]。由表4可知,IMAU13337对头孢唑林、庆大霉素、卡那霉素和四环素耐药,对其余16种抗生素均敏感。李宇行等[33]对62株乳酸菌菌株进行耐药性实验,发现有些乳酸菌对庆大霉素、四环素和卡那霉素等均有耐药性,并且乳酸菌对庆大霉素、卡那霉素和四环素的耐药性比较普遍[34]。与本研究的结果一致。
表4 药敏试验结果
Table 4 Results of drug sensitivity test

注:R表示耐药;I表示中敏;S表示敏感。
抗菌药物判断标准/mmRIS抑菌圈直径/mm耐药性青霉素 ≤1314^16≥1714I苯唑西林 ≤1011^12≥1320S氨苄西林≤1112^14≥1525S羧苄西林 ≤1920^22≥2320I哌拉西林 ≤1718^20≥2124S头孢氨苄 ≤1415^17≥1820S头孢唑林 ≤1415^17≥1814R头孢拉定 ≤1415^17≥1818S头孢呋辛 ≤1415^17≥1815I头孢他啶≤1415^17≥1816I头孢曲松≤1314^20≥2119I头孢哌酮≤1516^20≥2121S丁胺卡那 ≤1415^16≥1715I庆大霉素≤1213^14≥157R卡那霉素≤1314^17≥187R新霉素≤1415^17≥1820S四环素 ≤1415^18≥197R多西环素≤1213^15≥1619S米诺环素 ≤1415^18≥1920S红霉素 ≤1314^22≥2320I
2.6.2 溶血性试验
联合国农粮组织规定添加到食品中的益生菌不得具有溶血性,因为危害人类健康的溶血性细菌可以通过产生溶血素将细胞损坏并抑制免疫反应,引发败血症等疾病[35]。试验结果如图5所示,阳性对照菌ATCC 12600T金黄色葡萄球菌是β-溶血,周围有明显的透明圈,而L.paracasei IMAU13337周围未出现透明圈。因此,IMAU13337没有引起溶血现象且呈阴性,为γ-溶血。
a-阳性对照;b-IMAU13337
图5 溶血性试验结果
Fig.5 The result of hemolytic test
3 结论
本研究采用纯培养技术从云南香格里拉地区10份牦牛乳中分离得到170株乳酸菌,经16S rRNA测序技术将其鉴定为7个属、9个种。其中L.helveticus的分离数量最多(占47.1%),为该地区牦牛乳样品中的优势菌种。经耐盐和潜在益生特性筛选实验,筛选得到一株具有较强盐耐受能力的菌株L.paracasei IMAU13337。菌株具有优良的胃肠道耐受能力和抑菌能力。对其进行安全性评价后发现,其对16种抗生素敏感,溶血性呈阴性。综上,本研究探究了云南香格里拉高海拔地区牦牛乳样品中可培养乳酸菌的组成,并获得了乳酸菌菌种资源,为耐盐乳酸菌发酵剂的开发提供菌种和基础数据。
[1] BURGAIN J, SCHER J, FRANCIUS G, et al.Lactic acid bacteria in dairy food:Surface characterization and interactions with food matrix components[J].Advances in Colloid and Interface Science, 2014, 213:21-35.
[2] 林松洋, 郝利民, 刘鑫, 等.乳酸菌耐盐分子机制研究进展[J].食品科学, 2018, 39(3):295-301.LIN S Y, HAO L M, LIU X, et al.Progress in molecular mechanism of salt tolerance in lactic acid bacteria[J].Food Science, 2018, 39(3):295-301.
[3] 刘廷菊. 贵州锦屏腌鱼微生物多样性分析及乳酸菌筛选[D].长沙:中南林业科技大学, 2022.LIU T J.Analysis of microbial diversity and screening of lactic acid bacteria in Guizhou Jin ping pickled fish[D].Changsha:Central South University of Forestry and Technology, 2022.
[4] 曲玲童. 锦州腌渍小黄瓜中耐盐性乳酸菌的分离鉴定与性能研究[D].锦州:渤海大学, 2012.QU L T.Isolation, identification and performance of salt-tolerant lactic acid bacteria from pickled cucumber in Jinzhou[D].Jinzhou:Bohai University, 2012.
[5] 万金敏, 杨丽娜, 葛武鹏, 等.西藏牦牛奶渣中优势乳酸菌产胞外多糖及其耐受性[J].食品科学, 2017, 38(10):98-103.WAN J M, YANG L N, GE W P, et al.Exopolysaccharide(EPS)-producing ability and tolerance of dominant lactic acid bacteria(LAB) strains from yak milk dreg in Tibet[J].Food Science, 2017, 38(10):98-103.
[6] 文华英, 贾福晨, 靳玉龙, 等.西藏传统发酵酸奶源低温乳酸菌的筛选[J].中国乳业, 2022(5):89-95.WEN H Y, JIA F C, JIN Y L, et al.Screening of low-temperature lactic acid bacteria from Tibetan traditional fermented yogurt[J].China Dairy, 2022(5):89-95.
[7] HASSAN M U, NAYAB H, SHAFIQUE F, et al.Probiotic properties of Lactobacillus helveticus and Lactobacillus plantarum isolated from traditional Pakistani yoghurt[J].BioMed Research International, 2020, 2020:8889198.
[8] 娄新建, 郝力壮, 刘书杰, 等.牦牛乳营养价值的研究进展[J].动物营养学报, 2024, 36(3):1446-1462.LOU X J, HAO L Z, LIU S J, et al.Research progress on nutritional value of yak milk[J].Chinese Journal of Animal Nutrition, 2024, 36(3):1446-1462.
[9] 刘怡雯, 达久阿达, 张敏, 等.牦牛酸乳中乳酸菌的研究进展[J].乳品与人类, 2024(4):37-41.LIU Y W, DA J A D, ZHANG M, et al.Research progress of lactic acid bacteria in yak yoghurt[J].Dairy and Humankind, 2024(4):37-41.
[10] 雷善钰. 川西高原牦牛乳奶酪中乳酸菌的多样性及抗生素适应性进化研究[D].雅安:四川农业大学, 2023.LEI S Y.Study on the diversity of lactic acid bacteria and adaptive evolution of antibiotics in yak milk cheese in western Sichuan Plateau[D].Ya’an:Sichuan Agricultural University, 2023.
[11] 高利娥. 青藏高原传统发酵牦牛乳中乳酸菌的多样性及抗氧化特性研究[D].兰州:兰州大学, 2020.GAO L E.Study on the diversity and antioxidant properties of lactic acid bacteria in traditional fermented yak milk in Qinghai-Tibet Plateau[D].Lanzhou:Lanzhou University, 2020.
[12] YU J, WANG H M, ZHA M S, et al.Molecular identification and quantification of lactic acid bacteria in traditional fermented dairy foods of Russia[J].Journal of Dairy Science, 2015, 98(8):5143-5154.
[13] YU J, GAO W, QING M J, et al.Identification and characterization of lactic acid bacteria isolated from traditional pickles in Sichuan, China[J].The Journal of General and Applied Microbiology, 2012, 58(3):163-172.
[14] KUMAR S, STECHER G, TAMURA K.MEGA7: Molecular evolutionary genetics analysis version 7.0 for bigger datasets[J].Molecular Biology and Evolution, 2016, 33(7):1870-1874.
[15] 杨雄州, 王昊乾, 张静雯, 等.乳酸盐与渗透胁迫对干酪乳酪杆菌Zhang的损伤机理及保护措施[J].中国食品学报, 2024, 24(4):108-117.YANG X Z, WANG H Q, ZHANG J W, et al.Damage mechanism and protective measures of lactate and osmotic stress on Lactobacillus casei Zhang[J].Journal of Chinese Institute of Food Science and Technology, 2024, 24(4):108-117.
[16] WANG P P, WU Z, WU J, et al.Effects of salt stress on carbohydrate metabolism of Lactobacillus plantarum ATCC 14917[J].Current Microbiology, 2016,73(4):491-497.
[17] LIU W J, CHEN M X, DUO L N, et al.Characterization of potentially probiotic lactic acid bacteria and bifidobacteria isolated from human colostrum[J].Journal of Dairy Science, 2020, 103(5):4013-4025.
[18] WANG X, WANG W D, LV H X, et al.Probiotic potential and wide-spectrum antimicrobial activity of lactic acid bacteria isolated from infant feces[J].Probiotics and Antimicrobial Proteins, 2021, 13(1):90-101.
[19] 周闯, 宋俊雅, 叶菁, 等.1株马乳酒样乳杆菌的分离鉴定及益生特性研究[J].中国畜牧兽医, 2023, 50(7):2974-2986.ZHOU C, SONG J Y, YE J, et.al.Isolation, identification and probiotic properties of a strain of Lactobacillus kefiranofaciens[J].China Animal Husbandry &Veterinary Medicine, 2023, 50(7):2974-2986.
[20] 郑柳青, 刘冬梅, 张馨月, 等.鼠李糖乳杆菌LR-ZB1107-01的安全性评价及其益生特性初步研究[J].食品工业科技, 2020, 41(11):111-116.ZHENG L Q, LIU D M, ZHANG X Y, et al.Assessment of safety and probiotic characteristics of Lactobacillus rhamnosus ZB1107-01[J].Science and Technology of Food Industry, 2020, 41(11):111-116.
[21] LIU W J, SUN Z H, ZHANG J C, et al.Analysis of microbial composition in acid whey for dairy fan making in Yunnan by conventional method and 16S rRNA sequencing[J].Current Microbiology, 2009, 59(2):199-205.
[22] 杨子燕, 赵世伟, 杨绍芬, 等.云南迪庆传统发酵乳制品中乳酸菌多样性分析及具有发酵性能菌株的筛选[J].中国奶牛, 2016(7):44-49.YANG Z Y, ZHAO S W, YANG S F, et al.The biodiversity of lactic acid bacteria from traditional fermented milk of Yunnan Diqing and selection for good fermentation properties[J].China Dairy Cattle, 2016(7):44-49.
[23] TRIPATHI M K, GIRI S K.Probiotic functional foods:Survival of probiotics during processing and storage[J].Journal of Functional Foods, 2014, 9:225-241.
[24] ZHANG Y H, ZHANG Y P, ZHU Y, et al.Proteomic analyses to reveal the protective role of glutathione in resistance of Lactococcus lactis to osmotic stress[J].Applied and Environmental Microbiology, 2010, 76(10):3177-3186.
[25] 李佳莲. 耐盐乳酸菌的益生特性及其在食品发酵中的应用[D].无锡:江南大学, 2023.LI J L.Probiotics of salt-tolerant lactic acid bacteria and its application in food fermentation[D].Wuxi:Jiangnan University, 2023.
[26] 陈卫, 赵山山, 张秋香.乳酸菌的耐盐机制[J].中国食品学报, 2013, 13(10):1-7.CHEN W, ZHAO S S, ZHANG Q X.The mechanism of LAB to salt stress[J].Journal of Chinese Institute of Food Science and Technology, 2013, 13(10):1-7.
[27] 南晓芳. 豆豉和腐乳中耐盐乳酸菌的筛选、鉴定及其功能特性研究[D].呼和浩特:内蒙古农业大学, 2016.NAN X F.Screening, identification and functional characterization of salt-tolerant lactic acid bacteria in fermented bean and fermented bean curd[D].Hohhot:Inner Mongolia Agricultural University, 2016.
[28] 李梓铭.盐渍辣椒制品中耐盐乳酸菌筛选鉴定及其应用研究[D].长沙:湖南农业大学,2014.LI Z M.Screening, identification and application of salt-tolerant lactic acid bacteria in salted pepper products[D].Changsha:Hunan Agricultural University, 2014.
[29] 纪欣, 丛琳, 武岳, 等.耐受人工胃肠液双歧杆菌的体外筛选[C].第十五届益生菌与健康国际研讨会摘要集.江苏:2020.JI X, CONG L, WU Y, et al.Tolerate in vitro screening of bifidobacteria in artificial gastroenteric fluid[C].Summary of the 15th International Symposium on Probiotics and Health.Jiangsu,2020.
[30] 张和平, 孟和毕力格, 王俊国, 等.分离自内蒙古传统发酵酸马奶中L.casei Zhang潜在益生特性的研究[J].中国乳品工业, 2006, 34(4):4-10.ZHANG H P, MENG H, WANG J G, et al.Assessment of potential probiotic properties of L.casei Zhang strain isolated from traditionally home- made Koumiss in Inner Mongolia of China[J].China Dairy Industry, 2006, 34(4):4-10.
[31] CAMPANA R, VAN HEMERT S, BAFFONE W.Strain-specific probiotic properties of lactic acid bacteria and their interference with human intestinal pathogens invasion[J].Gut Pathogens, 2017, 9:12.
[32] KIM E, YANG S M, KIM H Y.Weissella and the two Janus faces of the genus[J].Applied Microbiology and Biotechnology, 2023, 107(4):1119-1127.
[33] 李宇行, 何继玮, 钱敏, 等.市售发酵食品中乳酸菌的耐药性评估及传播风险研究[J].食品与生物技术学报, 2024, 43(6):21-30.LI Y X, HE J W, QIAN M, et al.Antibiotics resistance evaluation and transmission risk of lactic acid bacteria in commercial fermented foods[J].Journal of Food Science and Biotechnology, 2024, 43(6):21-30.
[34] 塔娜. 酸马奶中乳酸菌的分离鉴定及其安全性评价试验[D].呼和浩特:内蒙古农业大学, 2022.TA N.Isolation and identification of lactic acid bacteria in koumiss and its safety evaluation test[D].Hohhot:Inner Mongolia Agricultural University, 2022.
[35] GANGULY N K, BHATTACHARYA S K, SESIKERAN B, et al.ICMR-DBT guidelines for evaluation of probiotics in food[J].Indian Journal of Medical Research, 2011, 134(7):22-25.